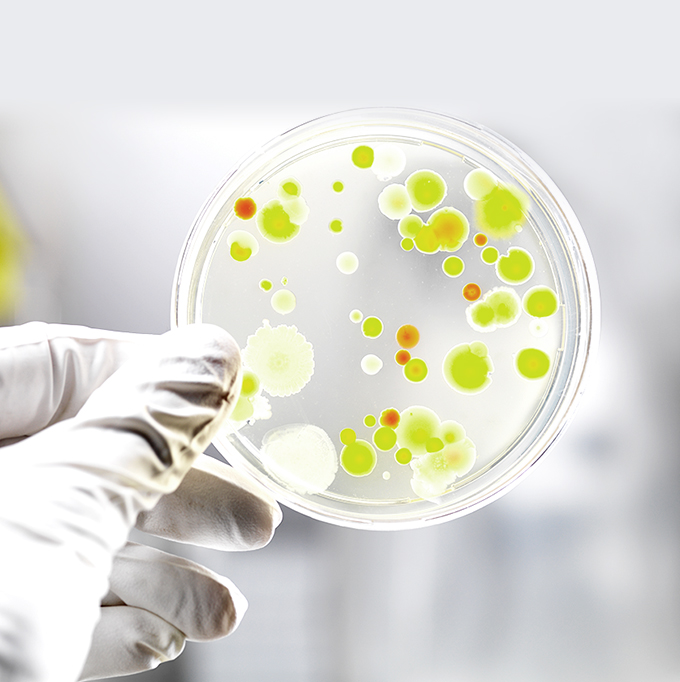

Bio Palette aims to become a world-leading company
in the field of microbiome therapeutics by using bacteria
optimized by genome editing to modify and control microbiomes.
Development of
Microbiome
Therapeutics
マイクロバイオーム治療の開発へ
バイオパレットは、ゲノム編集によって育種・改変した細菌を活用してマイクロバイオーム(細菌叢)の制御を実現し、マイクロバイオーム治療における世界のリーディングカンパニーとなることを目指しています。 Bio Palette aims to become a world-leading company in the field of microbiome therapeutics, utilizing genome-edited bacteria to control microbiome (bacterial flora).
-
-
What is Microbiome Therapeutics?
マイクロバイオーム治療とは
ヒトの健康状態や特定の疾患と関わりが深いマイクロバイオームを適切にコントロールする治療法が、次世代医療のひとつとして注目を集めています。 Therapeutics that properly controls microbiome, which is closely related to human health and specific diseases, has been attracting attention as one of the next-generation medical treatments.

-

-
-
-
Race for Commercialization
マイクロバイオーム治療の潮流
細菌を用いたマイクロバイオーム治療は「Living Medicine」とも呼ばれ、この新たな治療モダリティの実現に向けた開発が世界各国で進められています。 Microbiome therapeutics utilizing microbes, known as "living medicine", are being developed in many countries to realize this new modality of treatment.

-

-
-
-
Advantage of Base Editing
塩基編集が拓く新たなマイクロバイオーム治療
DNA二本鎖の切断を伴う「切るゲノム編集」と比べて、「切らないゲノム編集®」である塩基編集は細胞毒性が低く、細菌の遺伝子編集に適した技術です。 Compared to "Cutting” genome editing that involves DNA double-strand breaks, base editing is a technology with low cytotoxicity and is suitable for bacterial gene editing.

-

-
Technology
Target-AID®とTarget-G®
Target-AID® and Target-G®
バイオパレットのコア技術は、DNAを切断しない新しいゲノム編集(切らないゲノム編集®)です。CRISPR/Cas9に代表される従来のゲノム編集がヌクレアーゼによるDNA二本鎖の切断を前提としているのに対して、切らないゲノム編集®は塩基の変換を誘導する酵素(塩基変換酵素)により点変異を導入する技術です。 Bio Palette’s core technology is a new type of genome editing that does not involve DNA cleavage (so-called, “Non-Cutting” genome editing). While conventional genome editing using techniques such as CRISPR/Cas9 requires the DNA double strand to be cleaved with nuclease, “Non-Cutting” genome editing introduces point mutations using enzymes that induce base conversion (base converting enzymes).
より具体的には、CRISPRシステムのCas9タンパク質が有するヌクレアーゼ活性を不活性化し(dCas9またはnCas9)、塩基変換酵素と複合体を形成させることで、配列特異的にDNA上の特定領域に塩基変換酵素を作用させて点変異を導入するもので、この技術は一般的に塩基編集と呼ばれています。バイオパレットでは、塩基変換酵素の種類により、Target-AID®およびTarget-G®という2種類の塩基編集技術を有しています。 More specifically, by inactivating the nuclease activity of the Cas9 protein in the CRISPR system (dCas9 or nCas9) and forming a complex with a base converting enzyme, it introduces point mutations by causing base converting enzyme to act on a specific DNA region in a sequence-specific manner. This technology has become generally known as base editing. Bio Palette has two types of base editing technology, Target-AID® and Target-G®, each using a different type of base converting enzyme.





About us
会社概要
Company Profile
株式会社バイオパレットは、2017年2月に設立された
神戸大学大学院 科学技術イノベーション研究科発の
ゲノム編集バイオベンチャー企業です。
Bio Palette is a genome editing biotech start-up from Graduate School of Science, Technology and Innovation, Kobe University, established in February 2017.

News
-
- Apr 15, 2024
-
Appointment of New Directors
PDF -
- Jan 17, 2024
-
Bio Palette Strengthens Leadership Team with Key Appointments: Kazuko Ando as Executive Officer and CBO, Yoshinori Bamba as Executive Officer and COO, and Shinji Maeda as Auditor
PDF -
- Aug 24, 2022
-
Change of Representative Director
PDF -
- Aug 10, 2022
-
Research has been published by Kobe University on base editing technology
PDF -
- Oct 21, 2020
-
Selected as a "J-Startup KANSAI" Company
PDF -
- Sep 24, 2020
-
Bio Palette Raises $9.5M in Series A Financing
PDF -
- May 29, 2020
-
Fundamental Patent related to Base Editing Granted in the US and China
PDF -
- Oct 4, 2019
-
Fundamental Patent related to Base Editing Granted in Europe
PDF -
- May 31, 2019
-
Beam Therapeutics and Bio Palette Announce Exclusive License Agreements for Base Editing Technologies
PDF
Contact
バイオパレットへの各種お問い合わせおよび
パートナーシップのご相談はこちらからどうぞ。
For general inquiries or partnering requests,
get in touch with us from here.




